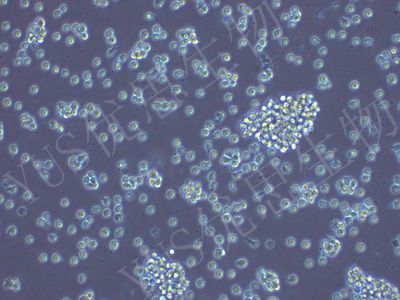

产品中心
产品中心
-

SW480 人结肠腺癌细胞(STR鉴定)
货号:YLH422规格: 1*10^6 -

SK-N-BE(2) 人神经母细胞瘤细胞(STR鉴定)
货号:YLH424规格: 1*10^6 -
NCI-H146 人小细胞肺癌细胞(STR鉴定)
货号:YLH425规格: 1*10^6 -

HeLa 人宫颈癌细胞(STR鉴定)
货号:YLH427规格: 1*10^6 -

Calu-3 人肺腺癌细胞(胸水)(STR鉴定)
货号:YLH428规格: 1*10^6 -

BALL-1 人B淋巴细胞白血病细胞(STR鉴定)
货号:YLH431规格: 1*10^6 -

NCI-H1650 人肺支气管癌细胞(STR鉴定)
货号:YLH432规格: 1*10^6 -

NCI-H292 人肺癌细胞(淋巴结转移)(STR鉴定)
货号:YLH433规格: 1*10^6 -

HCC1937 人乳腺癌细胞(STR鉴定)
货号:YLH434规格: 1*10^6 -

JIMT-1 人乳腺癌细胞(STR鉴定)
货号:YLH435规格: 1*10^6 -

NCI-H226 人肺鳞癌细胞(STR鉴定)
货号:YLH436规格: 1*10^6 -

22Rv1 人前列腺癌细胞(STR鉴定)
货号:YLH437规格: 1*10^6
在线咨询
Online consultation

关注微信公众号


